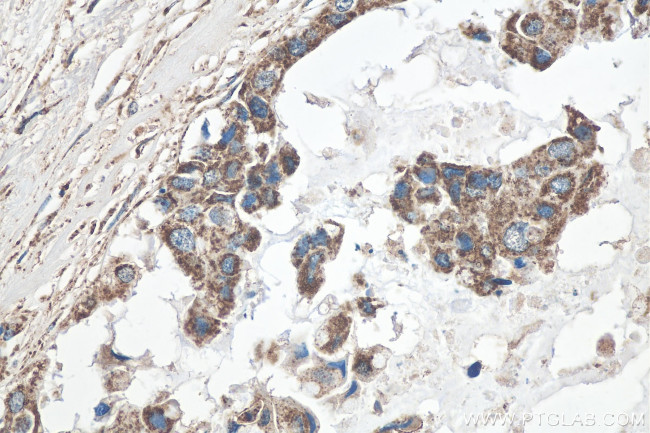
GLUD1 Antibody in Immunohistochemistry (Paraffin) (IHC (P))

Search
Proteintech
GLUD1 Polyclonal Antibody
{{$productOrderCtrl.translations['antibody.pdp.commerceCard.promotion.promotions']}}
{{$productOrderCtrl.translations['antibody.pdp.commerceCard.promotion.viewpromo']}}
{{$productOrderCtrl.translations['antibody.pdp.commerceCard.promotion.promocode']}}: {{promo.promoCode}} {{promo.promoTitle}} {{promo.promoDescription}}. {{$productOrderCtrl.translations['antibody.pdp.commerceCard.promotion.learnmore']}}
产品信息
14299-1-AP
种属反应
已发表种属
宿主/亚型
分类
类型
抗原
偶联物
形式
浓度
规格
纯化类型
保存液
内含物
保存条件
运输条件
产品详细信息
Immunogen sequence: FIGPGIDVP APDMSTGERE MSWIADTYAS TIGHYDINAH ACVTGKPISQ GGIHGRISAT GRGVFHGIEN FINEASYMSI LGMTPGFGDK TFVVQGFGNV GLHSMRYLHR FGAKCIAVGE SDGSIWNPDG IDPKELEDFK LQHGSILGFP KAKPYEGSIL EADCDILIPA ASEKQLTKSN APRVKAKIIA EGANGPTTPE ADKIFLERNI MVIPDLYLNA GGVTVSYFEW LKNLNHVSYG RLTFKYERDS NYHLLMSVQE SLERKFGKHG GTIPIVPTAE FQDRISGASE KDIVHSGLAY TMERSARQIM RTAMKYNLGL DLRTAAYVNA IEKVFKVYNE AGVTFT (214-558 aa encoded by BC040132)
靶标信息
Glutamate dehydrogenase, GluD1, is a mitochondrial matrix enzyme that catalyzes the oxidative deamination of glutamate to alpha-ketoglutarate and ammonia. This enzyme has an important role in regulating amino acid-induced insulin secretion. It is allosterically activated by ADP and inhibited by GTP and ATP. Activating mutations in this gene are a common cause of congenital hyperinsulinism. Alternative splicing of this gene results in multiple transcript variants. The related glutamate dehydrogenase 2 gene on the human X-chromosome originated from this gene via retrotransposition and encodes a soluble form of glutamate dehydrogenase. Related pseudogenes have been identified on chromosomes 10, 18 and X.
仅用于科研。不用于诊断过程。未经明确授权不得转售。
生物信息学
蛋白别名: epididymis secretory sperm binding protein; epididymis tissue sperm binding protein Li 18mP; GDH 1; glutamate dehydrogenase; glutamate dehydrogenase (NAD(P)+); Glutamate dehydrogenase 1, mitochondrial; glutamate dehydrogenase precursor; glutamate dehydrogenase precursor (EC 1.4.1.3.); Memory-related gene 2 protein; MRG-2; unnamed protein product
基因别名: Ac2-281; AI118167; GDH; Gdh-X; GDH1; GLUD; GLUD1; Gludeha; Gludl; hGDH1; MRG-2
UniProt ID: (Human) P00367, (Mouse) P26443, (Rat) P10860
Entrez Gene ID: (Human) 2746, (Mouse) 14661, (Rat) 24399